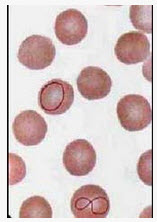

如图所示的异常红细胞结构常见于下列哪些疾病()
A . 蚕豆病
B . 巨幼红细胞性贫血
C . 溶血性贫血
D . 红白血病
E . 再生障碍性贫血
[多选题] 如图所示的异常红细胞结构常见于下列哪些疾病()A .蚕豆病B .巨幼红细胞性贫血C .溶血性贫血D .红白血病E .再生障碍性贫血
[多选题] 如图所示的异常红细胞结构可见于下列哪些疾病()A . 溶血性贫血B . 巨幼红细胞性贫血C . 脾切除术后D . 铅中毒E . 缺铁性贫血
[多选题] 如图所示的异常红细胞结构可见于下列哪些疾病()A .溶血性贫血B .巨幼红细胞性贫血C .脾切除术后D .铅中毒E .缺铁性贫血
[单选题]如图所示的异常红细胞结构常见于下列哪些疾病 ( )A.蚕豆病B.巨幼红细胞性贫血C.溶血性贫血D.红白血病E.再生障碍性贫血
[多选题] 如图所示的异常红细胞可见于哪些疾病()A . 再障B . 巨幼细胞贫血C . 骨髓纤维化D . 铅中毒E . 缺铁性贫血
[多选题] 如图所示的异常红细胞可见于哪些疾病()A .再障B .巨幼细胞贫血C .骨髓纤维化D .铅中毒E .缺铁性贫血
[单选题]如图所示的异常红细胞结构可见于下列哪些疾病 ( )A.溶血性贫血B.巨幼红细胞性贫血C.脾切除术后D.铅中毒E.缺铁性贫血
[填空题] 如图所示体征称为_____________,常见于_____________疾病。
[多选题]如图所示的异常红细胞结构常见于下列哪些疾病()A.蚕豆病B.巨幼红细胞性贫血C.溶血性贫血D.红白血病E.再生障碍性贫血
[多选题]如图所示的异常红细胞结构常见于下列哪些疾病()A.蚕豆病B.巨幼红细胞性贫血C.溶血性贫血D.红白血病E.再生障碍性贫血